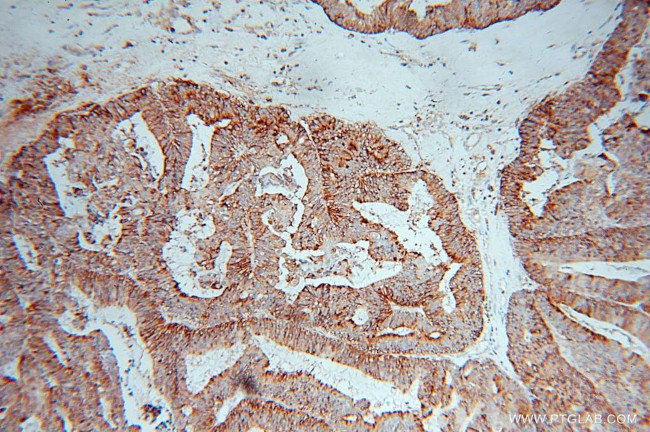
ARTS1 Antibody in Immunohistochemistry (Paraffin) (IHC (P))

Search
Proteintech
ARTS1 Polyclonal Antibody
{{$productOrderCtrl.translations['antibody.pdp.commerceCard.promotion.promotions']}}
{{$productOrderCtrl.translations['antibody.pdp.commerceCard.promotion.viewpromo']}}
{{$productOrderCtrl.translations['antibody.pdp.commerceCard.promotion.promocode']}}: {{promo.promoCode}} {{promo.promoTitle}} {{promo.promoDescription}}. {{$productOrderCtrl.translations['antibody.pdp.commerceCard.promotion.learnmore']}}
产品信息
13821-1-AP
种属反应
已发表种属
宿主/亚型
分类
类型
抗原
偶联物
形式
浓度
规格
纯化类型
保存液
内含物
保存条件
运输条件
产品详细信息
Immunogen sequence: NAFQLVSIG KLSIEKALDL SLYLKHETEI MPVFQGLNEL IPMYKLMEKR DMNEVETQFK AFLIRLLRDL IDKQTWTDEG SVSERMLRSQ LLLLACVHNY QPCVQRAEGY FRKWKESNGN LSLPVDVTLA VFAVGAQSTE GWDFLYSKYQ FSLSSTEKSQ IEFALCRTQN KEKLQWLLDE SFKGDKIKTQ EFPQILTLIG RNPVGYPLAW QFLRKNWNKL VQKFELGSSS IAHMVMGTTN QFSTRTRLEE VKGFFSSLKE NGSQLRCVQQ TIETIEENIG WMDKNFDKIR VWLQSEKLER M (642-941 aa encoded by BC030775)
靶标信息
The endoplasmic reticulum (ER) aminopeptidase 1 (ERAP1) is a 120 kDa protein localized to the lumen of the ER, which removes NH2-terminal residues from many antigenic precursors for MHC class I peptide presentation. Peptides that are presented by MHC class I on the surface of a cell must be 8-11 residues long, and ERAP1 specifically trims peptides of 9 amino acids or more. ERAP1 is also induced by interferon- gamma. The gene encoding human ERAP1 maps to chromosome 5q15. ERAP1 has previously been characterized as adipocyte-derived leucine aminopeptidase (A-LAP), puromycin-insensitive leucine-specific aminopeptidase (PILS-AP) and aminopeptidase regulator of TNFR1 shedding (ARTS-1). A-LAP is thought to inactivate several bioactive peptides, including angiotensin II and, subsequently, may be involved in the regulation of blood pressure. PILS-AP is described as playing a role in angiogenesis by regulating the proliferation and migration of endothelial cells, and ARTS-1 is characterized as a TNFR1 binding protein that promotes TNFR1 shedding. Further research will be necessary to fully elucidate the functions of this protein.
仅用于科研。不用于诊断过程。未经明确授权不得转售。
生物信息学
蛋白别名: A-LAP; Adipocyte-derived leucine aminopeptidase; Aminopeptidase PILS; aminopeptidase regulator of TNFR1 shedding; ARTS-1; Endoplasmic reticulum aminopeptidase 1; endoplasmic reticulum aminopeptidase associated with antigen processing; ER-aminopeptidase 1; leucyl-specific aminopeptidase PILS; metallopeptidase; family M1; PILS-AP; Puromycin-insensitive leucyl-specific aminopeptidase; Type 1 tumor necrosis factor receptor shedding aminopeptidase regulator; unnamed protein product; VEGF-induced aminopeptidase
基因别名: A-LAP; ALAP; APPILS; ARTS-1; ARTS1; ERAAP; ERAAP1; ERAP1; KIAA0525; PILS-AP; PILSA; PILSAP; UNQ584/PRO1154
UniProt ID: (Human) Q9NZ08, (Mouse) Q9EQH2
Entrez Gene ID: (Human) 51752, (Rat) 80897, (Mouse) 80898